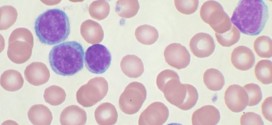

El edulcorante artificial ASPARTAME, o conocido por los nombres comerciales de NutraSweet/Equal/Spoonful/E951/Canderel/Benevia y otros es un veneno neurotóxico muy peligroso contenido en más de 5000 productos de consumo usual, especialmente en aquellos que se supone mantienen la línea (light). El estudio de la FUNDACION EUROPEA B.RAMAZZINI dedicada al estudio del cáncer ha demostrado que en dosis más bajas de la …
Leer MásResultados de: leucemia
¿ES EL ENSUCIAMIENTO CELULAR LA CAUSA DE MUCHOS CÁNCERES?
Para el doctor Jean Seignalet –conocido autor del libro La alimentación, la 3ª Medicina- el “ensuciamiento de las células” es la principal causa de la mayoría de las enfermedades reumatológicas, neuropsiquiátricas y autoinmunes además de ser el origen de más del 65% de los cánceres, entre otras patologías. “Ensuciamiento” que provoca los daños en el ADN que lleva a las …
Leer MásVITAMINAS
Principios inmediatos contenidos en los tejidos animales y vegetales y que, aunque aportados en cantidades generalmente mínimas por la alimentación (del orden de la millonésima o diezmillonésima parte de la ración alimenticia diaria) se muestran indispensables para el desarrollo de los actos visuales (asimilación, desarrollo, mantenimiento, funcionamiento, reproducción, etc.) y cuta ausencia se traduce en la aparición de una enfermedad, denominada carencial …
Leer MásLEUCEMIA
La leucemia es una enfermedad neoplásica de los órganos formadores de las células sanguíneas, caracterizada especialmente por la proliferación maligna de leucocitos o de sus precursores en la médula ósea y sangre periférica. Durante los primeros años de vida de una persona, las células normales se dividen más rápidamente para permitir el crecimiento. El cuerpo está compuesto por billones …
Leer MásCÁNCER
El cáncer. Los canceres se dividen en dos-tres grandes categorías de carcinoma y adenocarcinoma u otros. La característica básica de la malignidad es una anormalidad de las células, transmitida a las células hijas, que se manifiesta por la reducción del control del crecimiento y la función celular, conduciendo a una serie de fenómenos adversos en el huésped, a través de …
Leer MásInformación completa
Información completa La información completa es para que ustedes tengan más información sobre la trofología/higienista (TH), este tipo de terapia de la madre naturaleza, es muy vieja pero lo es mucho más su extremada eficacia para aliviar y curar la mayoría de las enfermedades y sin efectos secundarios, que más se puede pedir a un tratamiento eficaz y veraz, …
Leer Más Binipatia e higienismo Medicina natural alternativa, plantas medicinales y remedios caseros naturales
Binipatia e higienismo Medicina natural alternativa, plantas medicinales y remedios caseros naturales